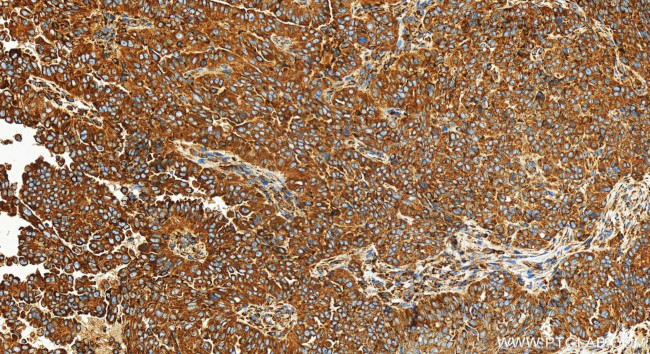
SENP1 Antibody in Immunohistochemistry (Paraffin) (IHC (P))

Search
Proteintech
SENP1 Recombinant Rabbit Monoclonal Antibody (240478D3)
{{$productOrderCtrl.translations['antibody.pdp.commerceCard.promotion.promotions']}}
{{$productOrderCtrl.translations['antibody.pdp.commerceCard.promotion.viewpromo']}}
{{$productOrderCtrl.translations['antibody.pdp.commerceCard.promotion.promocode']}}: {{promo.promoCode}} {{promo.promoTitle}} {{promo.promoDescription}}. {{$productOrderCtrl.translations['antibody.pdp.commerceCard.promotion.learnmore']}}
产品信息
83594-4-RR
种属反应
宿主/亚型
Expression System
分类
类型
克隆号
抗原
偶联物
形式
浓度
纯化类型
保存液
内含物
保存条件
运输条件
产品详细信息
Immunogen sequence: MDDIADRMRM DAGEVTLVNH NSVFKTHLLP QTGFPEDQLS LSDQQILSSR QGHLDRSFTC STRSAAYNPS YYSDNPSSDS FLGSGDLRTF GQSANGQWRN STPSSSSSLQ KSRNSRSLYL ETRKTSSGLS NSFAGKSNHH CHVSAYEKSF PIKPVPSPSW SGSCRRSLLS PKKTQRRHVS TAEETVQEEE REVYRQLLQM VTGKQFTIAK PTTHFPLHLS RCLSSSKNTL KDSLFKNGNS CASQIIGSDT SSSGSASILT NQEQLSHSVY SLSSYTPDVA FGSKDSGTLH HPHHHHSVPH QPDNLAASNT QSEGSDSVIL LKVKDSQTPT P
靶标信息
SENP1 is a protease that catalyzes two essential functions in the SUMO pathway: processing of full-length SUMO1, SUMO2 and SUMO3 to their mature forms and deconjugation of SUMO1, SUMO2 and SUMO3 from targeted proteins. SENP deconjugates SUMO1 from HIPK2 and from HDAC1, which decreases the transcriptional repression activity of the latter.
仅用于科研。不用于诊断过程。未经明确授权不得转售。
篇参考文献 (0)
生物信息学
蛋白别名: SEN1; Sentrin-specific protease 1; Sentrin/SUMO-specific protease SENP1; SUMO-1 protease 2; SUMO1/sentrin specific peptidase 1; SUMO1/sentrin specific protease 1; Sumo1/sentrin/SMT3 specific peptidase 1; SuPr-2
基因别名: 2310046A20Rik; D15Ertd528e; E330036L07Rik; SENP1; SuPr-2; Supr2
UniProt ID: (Human) Q9P0U3, (Mouse) P59110
Entrez Gene ID: (Human) 29843, (Mouse) 223870, (Rat) 300193